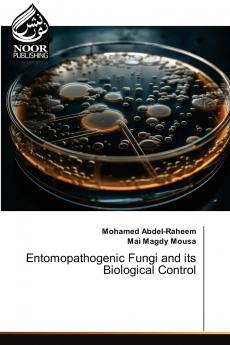
Entomopathogenic Fungi and its Biological Control

English
Paperback
₹5607
₹7344
23.65% OFF
(All inclusive*)
Delivery Options
Please enter pincode to check delivery time.
*COD & Shipping Charges may apply on certain items.
Review final details at checkout.
Looking to place a bulk order? SUBMIT DETAILS
About The Book
Description
Author(s)
Entomopathogenic fungi are considered as essential natural regulators in population of different insects. These fungi have potential as mycoinsecticide agents alongside different agricultural insect pests. The mode of actions of these fungi mainly cause infection in body of their host through cuticle penetration acquisition entrance to the host hemolymph production of toxins and grow by consuming nutrients which are existing in the hemocoel to avoid immune responses in insects. A total of 1600 different types of viruses are involved in the infection of 1100 different species of insects and mites. The fungi produce spores which infect their host by germinating on its surface and then growing into its body. Death takes between 4 and 10 days depending on the type of fungus and the number of infecting spores. After death the fungus produces thousands of new spores on the dead body which disperse and continue their life cycle on new hosts. There are two main taxonomic orders of entomopathogenic fungi. These fungi often cause natural epizootics in insect and mite populations.
Delivery Options
Please enter pincode to check delivery time.
*COD & Shipping Charges may apply on certain items.
Review final details at checkout.
Details
ISBN 13
9786208870522
Publication Date
-02-05-2025
Pages
-180
Weight
-252 grams
Dimensions
-152x229x10.53 mm